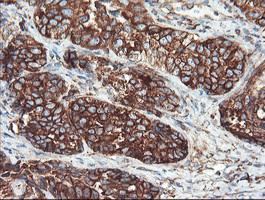

推荐应用
Deubiquitinase involved both in the processing of ubiquitin precursors and of ubiquitinated proteins. May therefore play an important role regulatory role at the level of protein turnover by preventing degradation of proteins through the removal of conjugated ubiquitin.
推荐稀释比 WB:1/500-1/1000;IHC:1/50-1/100
Immunohistochemistry analysis of paraffin-embedded Adenocarcinoma of Human ovary tissue using USP9X antibody.High-pressure and temperature Sodium Citrate pH 6.0 was used for antigen retrieval.
-25 ~ -15℃保存,收到货之后有效期1年,避免反复冻融。
【应用方向】抗体应用研究—心肌发育的分子解析与前沿转化
14880
2026-04-14
【应用方向】胚胎干细胞与诱导多能干细胞应用抗体推荐
19442
2026-04-14
【应用方向】间充质干细胞(MSC)应用研究抗体推荐—用于表型表征、机制研究与分化评估的常用靶标与抗体选型参考
20012
2026-04-14
【应用方向】抗体应用研究—细胞死亡
20044
2026-04-14
【应用方向】经典信号通路-JAK/STAT信号转导通路及抗体推荐
13036
2026-04-14
【应用方向】抗体应用研究—癌症疾病
17678
2026-04-15
【技术讲解】选对标签抗体,蛋白研究不用愁!
15828
2026-04-14
【选购指南】内参标签抗体选购指南
20790
2026-04-15
【技术讲解】如何选择合适的二抗
10579
2026-04-15





